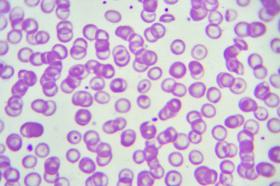

Talasemia
Talasemia. La talasemia es un trastorno sanguíneo hereditario que hace que tu cuerpo tenga menos hemoglobina de lo normal. La hemoglobina permite que los glóbulos rojos transporten oxígeno. La talasemia puede causar anemia, lo que te hace sentir con fatiga.
En esta forma hereditaria de anemia se reduce la síntesis de una o más de las cuatro cadenas de la hemoglobina, por lo general la 2 y la 2 , que forman parte de la hemoglobina en los glóbulos rojos de la sangre. Como la función de la hemoglobina es transportar el oxígeno desde los pulmones hacia los tejidos corporales. En la anemia ésta función es insuficiente para satisfacer las necesidades de los tejidos (por ejemplo: los músculos y el cerebro).
La palabra talasemia procede del griego y significa mar. Este trastorno se denominó así porque es más frecuente en las personas de origen mediterráneo. Sin embargo, su distribución es mundial.
Sumario
Tipos de Talasemia
Existen dos tipos principales de Talasemia, la Talasemia Alfa y la Talasemia Beta.
El primer tipo es la "Talasemia alfa" o Alfa-Talasemia, ocurre cuando un gen o los cuatro genes relacionados con la proteína hemoglobina alfa faltan o han cambiado (mutado). Cada persona tiene 2 pares de genes de cada uno de los padres. Si sucede algún cambio en los genes entonces la enfermedad se muestra de diferentes formas o solo eres portador. Ejemplo:
- Si existe un gen mutado: No tendrá signos o síntomas de talasemia. Pero es portador de la enfermedad y puedes transmitirla a tus hijos.
- Si existen dos genes mutados: Los signos y síntomas de talasemia serán leves. Esta afección podría llamarse característica de alfa-talasemia.
- Si existen tres genes mutados: Los signos y síntomas serán de moderados a severos.
Es poco frecuente heredar cuatro genes mutados y cuando esto ocurre suele dar lugar a la muerte fetal o intrauterina. Los bebés que nacen con esta afección, a menudo mueren poco después del nacimiento o requieren terapia transfusional de por vida. En casos poco comunes, un niño nacido con esta afección puede ser tratado con transfusiones y un trasplante de células progenitoras (Antiguamente se le conocía como la enfermedad de los vampiros, ya que la persona que la padecía tenía un constante déficit y necesitaba transfusiones frecuentes de sangre).
La talasemia alfa se observa casi siempre con mayor frecuencia en personas del sudeste asiático, Medio Oriente, China y en personas de ascendencia africana.
El segundo tipo es la "Talasemia beta" o Beta-Talasemia, ocurre cuando defectos genéticos similares afectan la producción de la proteína hemoglobina beta. en este caso se recibe un gen de cada padre.
De esta forma es como se afectará una persona que herede:
- Un gen mutado: Tendrá signos y síntomas leves. Esta afección se denomina talasemia menor o beta talasemia.
- Dos genes mutados: Los signos y síntomas serán de moderados a graves. Esta afección se denomina talasemia mayor o Anemia de Cooley.
Los bebés que nazcan con dos genes defectuosos de beta-hemoglobina generalmente son saludables al nacer, pero desarrollan signos y síntomas dentro de los primeros dos años de vida. Una forma más leve, llamada Talasemia intermedia, también puede resultar de dos genes mutados.
La talasemia beta se observa en personas de origen mediterráneo. En menor grado, los chinos, otros asiáticos y afroamericanos pueden resultar afectados.
Hay muchas formas de talasemia y cada tipo tiene muchos subtipos diferentes. Tanto la talasemia alfa como la beta abarcan las siguientes dos formas:
- Talasemia mayor.
- Talasemia menor.
Solo en caso de heredar el gen defectuoso de ambos padres la persona padecerá de talasemia mayor.
La talasemia menor se presenta si uno recibe el gen defectuoso de solo uno de los padres. Las personas con esta forma del trastorno son portadores de la enfermedad y por lo regular no tienen síntomas.
La talasemia beta mayor también se denomina "Anemia de Cooley".
Otros tipos de Talasemia
- Talasemia homocigótica (Anemia de Cooley)]].
La talasemia homocigótica, es aquella en la que las dos copias del gen para una cadena de la hemoglobina son defectuosas, ocurre cuando no se sintetizan cadenas. Los síntomas aparecen en los primeros meses de vida después del parto. Si los pacientes afectados son diagnosticados cuando son bebés y se tratan con transfusiones sanguíneas regulares hasta la pubertad, los niños se desarrollan de forma adecuada. Sin embargo, al llegar a la pubertad pueden aparecer diferentes problemas hepáticos, cardíacos y endocrinos como consecuencia de la sobrecarga de hierro por las transfusiones. Suelen fallecer antes de los 30 años por alteraciones cardíacas.
En ausencia de transfusiones, el niño muere en el primer año de vida. Si recibe una cantidad insuficiente de transfusiones, puede desarrollar deformidades en el cráneo y huesos, lo que le confiere un aspecto mongoloide. Presentan el bazo más grande, anemia grave, infecciones de repetición y tendencia a la hemorragia. También aparece un retraso en el crecimiento y si alcanzan la adolescencia corren el riesgo de sufrir las mismas complicaciones por sobrecarga de hierro que los que reciben un número adecuado de transfusiones.
La talasemia heterocigótica aparece cuando sólo está afectada una de las copias del gen que codifica la cadena. Quienes la padecen no suelen presentar síntomas excepto durante el embarazo, en el que pueden presentar una anemia.
La talasemia puede producir dos trastornos principales. El más grave es el Síndrome hidrópico de Bart; el otro es la Enfermedad de la hemoglobina H.
El “Síndrome hidrópico de Bart”, (BTHS) es un error congénito del metabolismo de los fosfolípidos caracterizado por: miocardiopatía dilatada (CMD), miopatía esquelética, neutropenia, retraso en el crecimiento y aciduria orgánica, aparece cuando no se producen cadenas, incluso en el feto. Por lo general estos fetos nacen muertos hacia la 28 a 40 semanas y si nacen vivos, fallecen durante la primera hora.
La hemoglobina H está formada por cuatro cadenas normales. Se produce cierta cantidad de cadenas, pero no suficiente. Los síntomas no son tan graves como los de la talasemia, pero hay anemia y aumento de tamaño del bazo. Los pacientes suelen sobrevivir hasta la vida adulta.
Síntomas
Como existen diversos tipos de talasemia, los signos y síntomas que se pueden presentar dependen del tipo y la severidad de la afección.
Los signos y síntomas de la talasemia pueden incluir:
- Fatiga.
- Debilidad.
- Piel pálida o amarillenta.
- Deformidades óseas faciales.
- Crecimiento lento.
- Hinchazón abdominal.
- Orina oscura.
Algunos bebés muestran signos y síntomas de talasemia al nacer; otros los desarrollan durante los dos primeros años de vida. Algunas personas que solo tienen un gen de la hemoglobina afectado no tienen síntomas de la enfermedad.
Diagnóstico
Los médicos diagnostican talasemia mediante pruebas de sangre, logrando confirmar la presencia de la enfermedad y su diagnóstico cuando están presentes los siguientes resultados:
- Un nivel bajo de glóbulos rojos.
- Glóbulos rojos que son más pequeños de lo usual.
- Glóbulos rojos pálidos.
- Glóbulos rojos que varían en tamaño y forma.
- Glóbulos rojos con distribución irregular de hemoglobina, lo que les da la apariencia de un blanco al cual apuntar, visto bajo un microscopio.
También se pueden usar los análisis de sangre para:
- Medir la cantidad de hierro en la sangre de su hijo.
- Evaluar su hemoglobina.
- Hacer un análisis de ADN para diagnosticar talasemia o para determinar si una persona lleva genes mutados de hemoglobina.
Tratamiento
Los tratamientos incluyen transfusiones de sangre y procedimientos para eliminar el exceso de hierro del cuerpo. Si no tiene síntomas o son leves, puede que no necesite tratamiento. En algunos casos graves puede ser necesario un trasplante de médula ósea.
Al ser este un trastorno sanguíneo heredado que se da en los glóbulos rojos, estas células de la sangre son las encargadas de llevar el oxígeno por todo nuestro organismo y lo hacen junto a una proteína de los glóbulos rojos que se llama hemoglobina. La hemoglobina está compuesta a su vez por dos proteínas, la hemoglobina alfa y la hemoglobina beta. Y para la formación de hemoglobina, hace falta tener suficiente cantidad de hierro. En la talasemia se afecta una de estas proteínas, lo que hace que la hemoglobina tenga una composición diferente a la normal.
Esta enfermedad no es contagiosa. La talasemia es un trastorno genético que se hereda del padre, de la madre o de ambos.
La talasemia es una enfermedad autosómica recesiva. Esto quiere decir que hacen falta dos genes o más alterados para expresar la enfermedad, uno de la madre y otro del padre, etc.
Cuando el paciente tiene un solo gen alterado se habla de rasgo talasémico o talasemia menor, que es lo que pasa de forma más frecuente. En éste caso, el niño está totalmente sano o solo tiene una leve afectación. Si el niño hereda el gen afectado tanto del padre como de la madre, hecho poco probable, tiene una forma más grave de la talasemia, que es la talasemia mayor.
Regiones de origen
Las talasemias son más frecuentes entre las personas de ascendencia italiana, griega, del Medio Oriente, del sur de Asia y africana.
Regiones más comunes
Los continentes más afectados, con presencia de la enfermedad son Asia y Latinoamérica, aunque se estima que África pueda superar las cifras actuales si se recolectaran todos los datos necesarios.
- África.
- América.
- Europa.
- Asia.
Fuentes
http://www.nacersano.org/centro/9388_9980.asp La Talasemia]
http://www.fundatal.org.ar/talasemiamenor.htm La Talasemia]
http://www.saludinfantil.com/talasemia.htm La Talasemia]
http://www.familiaysalud.es/sintomas-y-enfermedades/corazon-y-sangre/la-sangre/que-es-la-talasemia
https://medlineplus.gov/spanish/thalassemia.html
https://medlineplus.gov/spanish/ency/article/000587.htm
https://es.wikipedia.org/wiki/Talasemia
https://www.mayoclinic.org/es-es/diseases-conditions/thalassemia/diagnosis-treatment/drc-20355001
